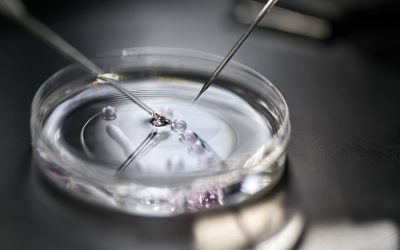
Metoda in vitro

Gabinet ginekologiczno-położniczy
lek. Włodzimierz Sajdak
O MNIE
Wykształcenie medyczne zdobyłem, kształcąc się w Pomorskiej Akademii Medycznej w Szczecinie, którą ukończyłem w 1991 roku. Kształciłem się pod okiem wybitnych specjalistów w tej dziedzinie, dzięki czemu dziś zarówno zdobytą wiedzę jak i budowane latami doświadczenie mogę wykorzystać we własnym gabinecie.
Aktualności
Choroby weneryczne – rodzaje, objawy, leczenie
Młodość jest czasem eksperymentowania – pierwszego zakochania, pierwszego pocałunku, pierwszego seksu. Często, w uniesieniu miłosnym, nie zdajemy sobie sprawy z konsekwencji jakie mogą iść za zbliżeniem. Co warto wiedzieć o chorobach wenerycznych, które mogą...
Jakie są różnice między niepłodnością a bezpłodnością?
Pojęcia niepłodności oraz bezpłodności często są mylone i utożsamiane. Tymczasem dotyczą dwóch odrębnych schorzeń, choć w zakresie tej samej kwestii: płodności. Niepłodność można leczyć, natomiast bezpłodność jest nieuleczalna i ciążę można uzyskać przez techniki...
Metoda in vitro
Metoda in vitro - w przeciwieństwie do inseminacji zapłodnienie in vitro jest metodą leczenia niełodności odbywającą się poza żeńskim układem rozrodczym. Inaczej nazywane zapłodnieniem pozaustrojowym, polega na połączeniu komórki jajowej z plemnikiem w warunkach...
Palenie papierosów a ciąża
Palenie papierosów niezmiennie pozostaje plagą społeczeństwa, przyczyniającą się do namnażania wielu chorób. Negatywne skutki wynikające z tego wyjątkowo szkodliwego nałogu można długo wymieniać, a większość z nich jest powszechnie znana. Nie zmienia to faktu, że...
Pochwica – przyczyny i leczenie
Pochwica to zaburzenie seksualne spotykane u kobiet, które polega na występowaniu skurczu mięśni pochwy, utrudniającym lub uniemożliwiającym odbycie stosunku seksualnego. Wpływ na jego pojawienie się mają czynniki fizyczne lub psychiczne. Wyjaśniamy, co to jest...
Seks to zdrowie! Redukcja stresu
Co się dzieje, gdy odczuwamy brak ochoty na seks? Nasze samopoczucie i zdrowie jest w znacznym stopniu związane z fizyczną odsłoną miłości. Zobacz, dlaczego seks to zdrowie. W każdym związku są lepsze i gorsze momenty, co przekłada się na aktywność...
Galeria zdjęć
W mojej ofercie
Moja wieloletnia praca w Szpitalu i zebrane doświadczenie pozwalają mi skoncentrować się na prowadzeniu ciąż oraz ocenie ryzyka wad genetycznych. Sprzęt medyczny, jakim dysponuje gabinet, umożliwia przeprowadzenie szybkiej i trafnej diagnozy oraz kompleksowego leczenia z pełnym panelem niezbędnych badań.
Poznaj cennik moich usług
Prowadzenie ciąży
Prowadzenie przeze mnie pacjentki ciężarnej obejmuje cykl wizyt lekarskich, od momentu stwierdzenia ciąży, do ostatniej wizyty, przed porodem.
Ciąża wysokiego ryzyka
W celu zminimalizowania zagrożeń i ich przeciwdziałaniu tworzony jest indywidualny model postępowania diagnostyczno-terapeutyczny.
Antykoncepcja
Wybór metody antykoncepcji to ważna decyzja, którą podejmować należy z uwzględnieniem rozmaitych czynników
Leczenie hormonalne okresu przekwitania
Hormonalna Terapia Zastępcza (w skrócie: HTZ) to rozwiązanie dla pacjentek, które odczuwają uciążliwe skutki uboczne okresu przekwitania
Zaburzenia miesiączkowania
Zaburzenia cyklu miesiączkowego mogą wynikać z rozmaitych przyczyn, związanych z przyjmowaniem leków czy nieprawidłowym odżywaniem.
Profilaktyka ginekologiczna
W prowadzonym gabinecie oferuję profilaktykę ginekologiczną w pełnym zakresie.